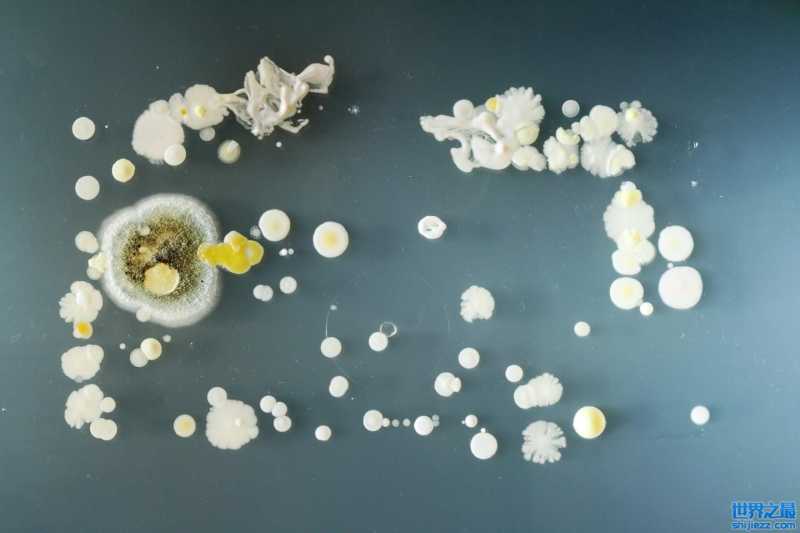
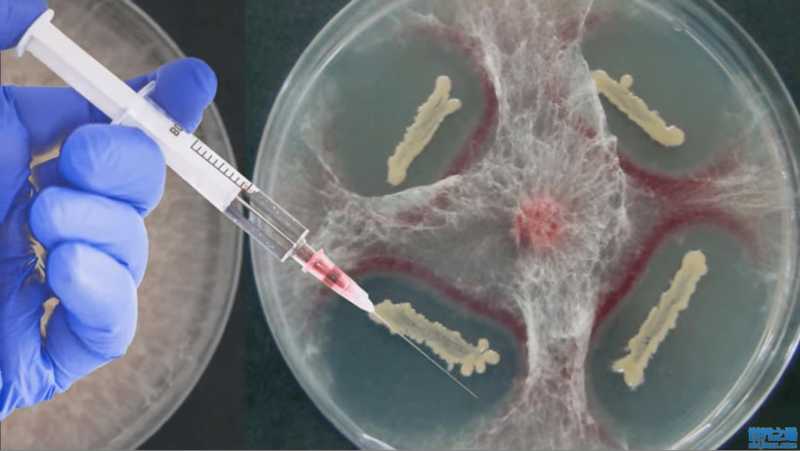

科学家有多疯狂?居然给自己注射细菌(永生实验)
F芽孢杆菌能让你长生不老?

说起来,这是也与当地气候环境污染相对较少有关。不过,俄罗斯科学家认为,古代雅库特人的长寿可能是因为古芽孢杆菌F的存在,原本与雅库特人没有任何联系,也应该是科学家为例,认为这是证明F芽孢杆菌能够获得永生的最好证据之一,所以多年前,科学家们想要进行人体试验,希望能有人自愿充当实验者,将F芽孢杆菌注射到体内。
大家都在看
-
趣话历史:那些鲜为人知的奇闻轶事 历史的长卷,总藏着许多让人忍俊不禁的精彩篇章,下面这些趣事,带你领略古人不为人知的一面。北宋词人柳永,堪称当时的 “流行音乐教父”。他的词通俗易懂,传唱度极高,上至王公贵族,下至市井百姓,都能哼上几句 ... 奇闻怪事05-08
-
中国古代野史五例奇闻异事 中国古代野史五例奇闻异事中国古代历史浩如烟海,正史之外,野史奇闻异事层出不穷,既有离奇怪诞的传说,也有耐人寻味的轶事,往往映射出当时社会的风貌与人情冷暖。以下五则野史奇闻,细节离奇,故事性强,既有神秘 ... 奇闻怪事05-07
-
世界之大无奇不有,26张照片带你看不一样的奇闻趣事 1.梦露为肯尼迪唱生日快乐歌的那个夜晚,裙子造价被精确记录到美分:1440美元33美分。五十四年后,2016年11月,这条裙子在拍卖会上以480万美元成交。2.在法国,“第一玫瑰”的名字几乎与苏菲·玛索画上了等号。岁月 ... 奇闻怪事05-01
-
民间奇闻:15年灵龟困树不死,三桩民间旧事,道尽天地禁忌宿命! 世间真有熬不死的生灵?能扛过十数载风霜雨雪,不吃不喝也能活命?老辈人传下的话,从来都不是随口瞎掰。南北朝大定年间,楚地岳州地界,荒岭连着黄河故道的余脉。土厚林密,山深雾重,藏着数不清凡人摸不透、说不破 ... 奇闻怪事04-26
-
民国奇闻:一口棺材密封数年,打开里面的鲤鱼还活着!冯国璋看傻 冯国璋民国年间,有一口棺材,离奇得让人后背发凉。话说冯国璋当上代总统之后,有个下属跑来送了他一口棺材。不是祝他“升官发财”那种吉利话,是真真切切的一口大棺材,用大红绸缎盖着,抬到了冯国璋的府上。冯国璋 ... 奇闻怪事04-26
-
袁世凯奇闻逸事 说起袁世凯,这人绝对是晚清民国头号搞笑枭雄,一身奇葩趣事特别的多,而且黑幽默居多! 他打小就是妥妥的学渣,科举考两次全都落榜,直接摆烂躺平,书一扔绝不死磕八股,转头跑去当兵,立志靠拳头和兵权闯天下。其 ... 奇闻怪事04-26
-
乡村奇闻异事 江苏徐州一个宁静的村庄里,一场原本遵循旧俗的百岁老人葬礼,猝不及防地演变成了一场令人头皮发麻又热泪盈眶的奇观。当起灵的哀乐响彻云霄,几名壮汉正准备抬起灵柩时,天空突然传来异样的低鸣。数十只体型硕大的飞 ... 奇闻怪事04-26
-
离谱又真实!全球奇闻趣事大赏,看完大开眼界 2026-04-24 17:00 · 奇闻趣事 · 原创 盘点近期全网刷屏的真实奇闻,每一件都离谱到像编故事,却件件有依据、能查证,看完忍不住感叹世界真奇妙! 一、国内硬核母爱:武汉妈妈花60万买1斤黄金当嫁妆 4月21日,武汉 ... 奇闻怪事04-25
-
世界之大无奇不有,带你了解不一样的奇闻趣事 世界之大无奇不有,带你了解不一样的奇闻趣事世界之大无奇不有,带你了解不一样的奇闻趣事昨晚刷手机刷到凌晨两点,我盯着刘亦菲那张脸,突然意识到一个恐怖的事实:我活了三十多年,居然连一只鸽子都不如。纽约地铁 ... 奇闻怪事04-17
-
奇闻异录500个故事 文/杨普义第一卷 古典志怪篇1. 干将莫邪铸剑复仇楚国巧匠干将、莫邪夫妇,耗时三年为楚王铸成雌雄双剑。楚王恼怒耗时太久,斩杀干将。干将之妻生下儿子赤鼻,赤鼻长大后得知身世,持父亲暗藏的雄剑,在侠客相助下, ... 奇闻怪事04-14
相关文章
- 世界之大无奇不有,带你了解不一样的奇闻趣事
- 奇闻异录500个故事
- 世界之大无奇不有,十八张照片带你看不一样的奇闻趣事
- 民间奇闻:女孩误入镜像时空门洞,选错一边后,亲人全都变了模样
- 世界之大无奇不有,十六张照片带你看不一样的奇闻趣事
- 村里老人说:没人敢讲的乡村奇闻真实经历
- 滑稽笑星舒悦的五大奇闻异事
- 民间奇闻探秘,被老人讳莫如深的3个鬼传闻,藏着不为人知的真相
- 我在乡下做了十年道士,笔记里记下的那些奇闻异事
- 论当代社会奇闻趣事
- 下班摸鱼必看!3个最新奇闻,每一个都刷新认知
- 分享你身边的奇闻异事
- 2月9日离谱奇闻合集!件件笑到捶桌,第3个太绝了
- 中国近代5桩野史奇闻:大师搓麻、太监掌权、民间神医断头还生
- 杭州发生过哪些奇闻异事?
- 野史揭秘:那些被正史藏起来的奇闻怪事,古人到底有多“疯狂”?
- ~奇闻趣事
- “曹禺真会‘读书’假洗澡?古代名人奇闻趣事大揭秘!”
- 分享一些你知道的民间奇闻异事
- 奇闻怪事:广德某妇得孕产蛇!
热门阅读
-
日本gv公司盘点,高质量钙片清秀型美攻美受 07-11
-
盘点中国十大龙现身事件,真龙竟然屡次现身震惊众人 06-27
-
戴旭说出马航失联真相,因为害怕承担责任迟迟不公开 07-05
